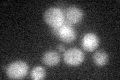
YKL201C
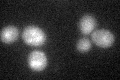
YKL201C

View description
Putative positive regulator of mannosylphosphate transferase (Mnn6p), involved in mannosylphosphorylation of N-linked oligosaccharides; expression increases in late-logarithmic and stationary growth phases
Localization:
Intensity:
Fold change:
Significance:
-
C’ GFP library in SD
below threshold18.17 -
N' NOP1pr-GFP in SD

N/A0 -
N' TEF2pr-mCherry in SD

N/A0 -
N' NATIVEpr-GFP in SD

N/A0 -
N' TEF2pr-VC and Cyto-VN in SD

N/A0 -
C’ GFP library in SD+DTT
cytosol19.791.08No -
C’ GFP library in SD+H2O2

cytosol16.590.91No -
C’ GFP library in Starvation Media

cytosol22.041.21No -
C’ GFP library on the background of Pup2-DaMP

below threshold -
C’ GFP library on the background of CCT mutant

below threshold15.85730.872476No
